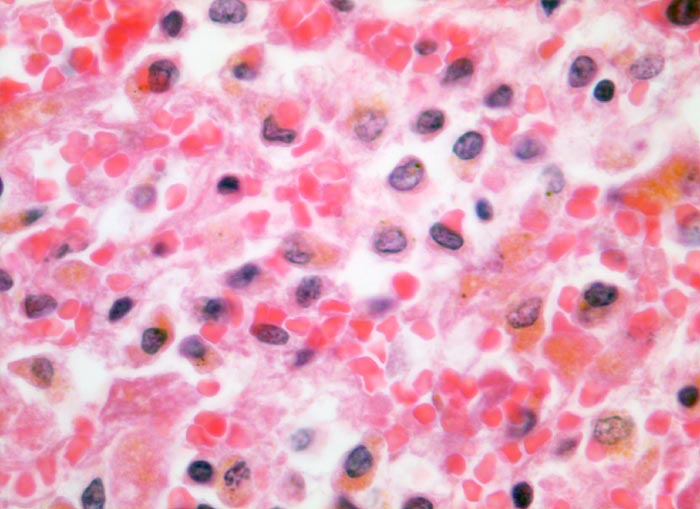

PathoPic – image database / PathoPic ID 3250 - Parenchymnekrose bei Schock
de
Diagnose
Parenchymnekrose bei Schock
Diagnose Gruppe
vaskulär / Durchblutungsstörung
Topographie
Leber
Topographie Gruppe
Leber, Gallenwege, Pankreas
Beschreibung
Ausschnitt aus der perivenulären Nekrosezone. Anstelle von Hepatozyten sind siderinbeladene Makrophagen mit braungefärbtem Zytoplasma getreten, welche die nekrotischen Hepatozyten phagozytiert haben. Die Makrophagen liegen eingebettet in ein blutreiches Maschenwerk aus Reticulinfasern. Einzelne blasse nekrotische Hepatozyten ohne erkennbare Kernstrukturen sind noch nicht abgebaut worden.
Klinik
Schweres akutes Rechtsherzversagen bei multiplen zentralen und perizentralen Lungenembolien.
Bilder Typ
Histologie
Vergrösserung
400
Alter
74
Geschlecht
unbekannt
Datum
Ersteintrag: 22.03.2002
Update: 04.02.2024